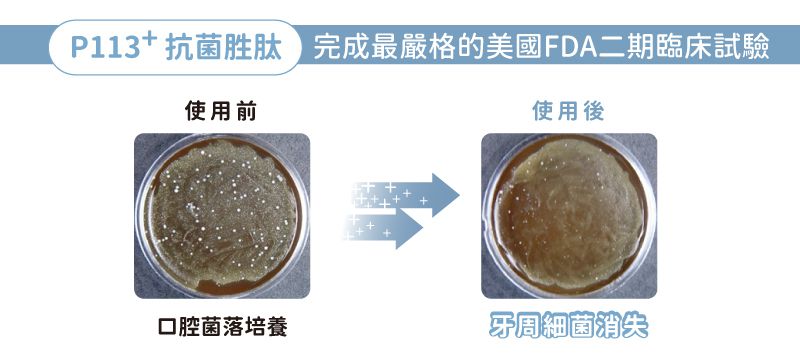
oh care 歐克威爾 - P113+抗菌胜肽 雙效兒童牙線棒-60入/盒

首載 App 現領 $ 100 折價券
 ( 10000+ )
( 10000+ )
1/1
商品特色
P113+抗菌胜肽 x 木糖醇
安全牙弓設計
無味無香料
符合人體工學握柄
全家人都適用

口碑嚴選

正品保證

加密付款

7天鑑賞
付款
信用卡・LINE Pay・街口支付・先享後付・ATM・貨到付款
配送
宅配
免運
超商取貨
免運
註冊新會員立即領首購免運券
33 則熱心媽咪評論
真實承諾
oh care 歐克威爾 - P113+抗菌胜肽 雙效兒童牙線棒-60入/盒
開始訓練寶貝開始牙齒健康,這個牙線棒很安全可以讓寶貝自己使用!
oh care 歐克威爾 - P113+抗菌胜肽 雙效兒童牙線棒-60入/盒
商品很不錯,使用起來很方便!下次會再回購
oh care 歐克威爾 - P113+抗菌胜肽 雙效兒童牙線棒-60入/盒
原本擔心寶寶不買單,但實際使用,寶寶接受度很高!推薦
oh care 歐克威爾 - P113+抗菌胜肽 雙效兒童牙線棒-60入/盒
小孩回饋順手好用,又可以對抗牙斑箘,大容量很划算!
oh care 歐克威爾 - P113+抗菌胜肽 雙效兒童牙線棒-60入/盒
牙線小巧、顏色繽紛還搭配動物圖案,小朋友用的很順手,每次拿到不同的動物增加潔牙的樂趣。
oh care 歐克威爾 - P113+抗菌胜肽 雙效兒童牙線棒-60入/盒
商品很棒會在回購,也會推薦也認識的人使用!
oh care 歐克威爾 - P113+抗菌胜肽 雙效兒童牙線棒-60入/盒
他們家的產品,我們家小孩從小用到大,什麼味道都很喜歡
oh care 歐克威爾 - P113+抗菌胜肽 雙效兒童牙線棒-60入/盒
可防止蛀牙
小小支對小孩很方便使用
很棒
oh care 歐克威爾 - P113+抗菌胜肽 雙效兒童牙線棒-60入/盒
還沒用,但家裡都會囤類似的,就試試看囉!
oh care 歐克威爾 - P113+抗菌胜肽 雙效兒童牙線棒-60入/盒
好用喔,安心使用不怕小朋友刺到嘴巴,也買多次了喔
oh care 歐克威爾 - P113+抗菌胜肽 雙效兒童牙線棒-60入/盒
可愛造型的牙線棒,每次使用前小朋友都會猜是什麼動物,增加潔牙的樂趣。
oh care 歐克威爾 - P113+抗菌胜肽 雙效兒童牙線棒-60入/盒
很好上手不會有卡住牙縫情況,小孩不排斥,也會想要自己動手練習剔牙。
介紹





/https://images.mamilove.com.tw/origin/itemIntro/415169/415169-4a5d6a913c-1633569285.gif)

看更多

